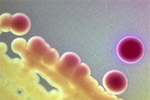

Ученые озабочены появлением новых микробов, устойчивых к антибиотикам Американское общество инфекционных болезней (АОИБ) настаивает на принятии федерального закона, который послужит стимулом для разработки новых антибиотиков фармацевтическими компаниями, сообщает UPI.
По данным АОИБ, в настоящее время существует семь микроорганизмов, представляющих наибольшую опасность вследствие лекарственной устойчивости. К ним относятся метициллин-резистентный стафилококк (Staphylococcus aureus), кишечная палочка (Escherichia coli), клебсиела (Klebsiella), Аcinetobacter baumannii, аспергилл (Aspergillus), ванкомицин-резистентный энтерококк (Enterococcus faecium) и синегнойная палочка (Pseudomonas aeruginosa). Борьба с ними сильно затруднена, поскольку имеется недостаточное количество или полностью отсутствуют эффективные лекарственные препараты.
«Это опасные для жизни инфекции, устойчивые к лекарствам, и мы встречаемся с ними ежедневно», - сообщил президент АОИБ Мартин Бласер (Martin Blaser). – «Хуже всего то, что существующие антимикробные средства перестают действовать, а новых препаратов не наблюдается».
В течение 20 лет наблюдалось неизменное снижение числа антимикробных средств, получивших одобрение Управления по пищевым продуктам и лекарственным средствам США (FDA), кроме того, многие средства были сняты с производства.
Зачастую от разработки до внедрения в производство новых лекарственных средств уходят многие годы. В связи с этим АОИБ призывает Конгресс США принять законопроект, предоставляющий льготы компаниям, вкладывающим средства в разработку, усовершенствование и производство новых видов антибиотиков. |